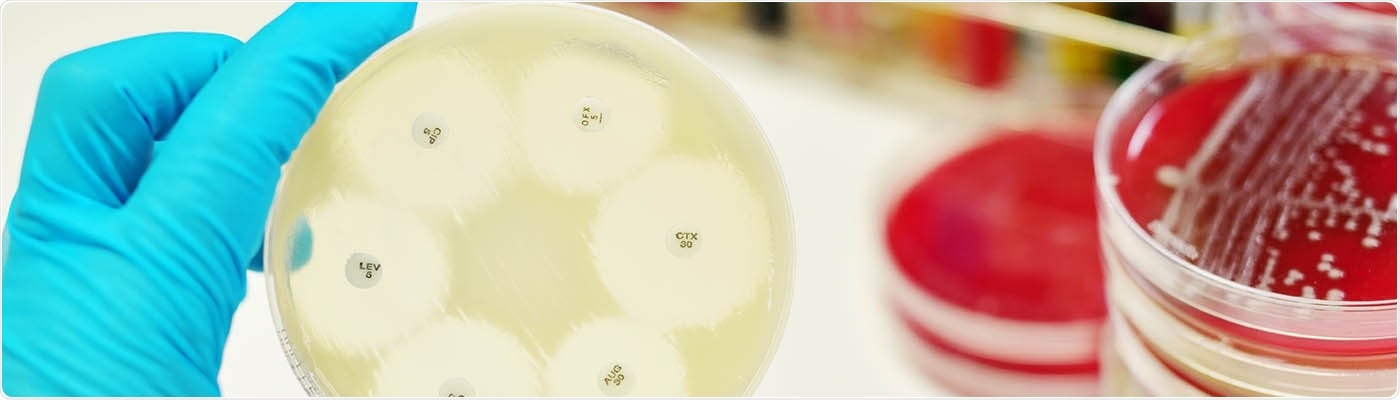

Researchers recently discovered a novel route to produce complex antibiotics taking advantage of gene editing to re-program pathways to future medicines instantly needed to treat neglected diseases, fight antimicrobial resistance, and handle future pandemics.
Image Credit: The University of Manchester.
Scientists from The University of Manchester identified a novel means of manipulating significant assembly line enzymes in bacteria which can lay the foundation for a new generation of antibiotic treatments.
The researchers elaborated how CRISPR-Cas9 gene editing can be utilized to generate new nonribosomal peptide synthetase (NRPS) enzymes that provide clinically significant antibiotics.
NRPS enzymes are prolific producers of natural antibiotics like penicillin. But, to date manipulating these complex enzymes to create new and efficient antibiotics has been a great challenge. The study was published on November 25th, 2021, in the Nature Communications journal.
The UK government states that antimicrobial resistance (AMR) infections are estimated to be the reason for over 700,000 deaths every year globally. It is anticipated to rise to 10 million, costing the world economy $100 trillion, by 2050. AMR also threatens the UN’s Sustainable Development Goals (SDGs), with an extra 28 million individuals who could be forced into severe poverty by 2050 if AMR is not contained.
The team from Manchester states that gene editing mechanisms can be utilized to produce enhanced antibiotics and possibly lead to the generation of novel treatments aiding in the combat against drug-resistant pathogens and illnesses in the future.
The emergence of antibiotic-resistant pathogens is one of the biggest threats we face today. The gene-editing approach we developed is a very efficient and rapid way to engineer complex assembly line enzymes that can produce new antibiotic structures with potentially improved properties.”
Jason Micklefield, Professor, Chemical Biology, Manchester Institute of Biotechnology
Microbes present in the environment like soil-dwelling bacteria evolved nonribosomal peptide synthetase enzymes (NRPS). These enzymes assemble building blocks known as peptide products which harbor very potent antibiotic activity. The majority of the therapeutically vital antibiotics utilized in the clinics are derived from these NRPS enzymes (for instance vancomycin, penicillin, and daptomycin).
However, deadly pathogens resistant to existing antibiotic drugs are emerging. One solution is to generate new antibiotics with enhanced properties that can avoid the resistance mechanisms of the pathogens.
But, the nonribosomal peptide antibiotics are highly complex structures expensive and difficult to create by normal chemical methods. As a solution, researchers from Manchester employed gene editing to engineer the NRPS enzymes. They swapped domains that identify various amino acid building blocks, resulting in new assembly lines that can provide new peptide products.
We are now able to use gene editing to introduce targeted changes to complex NRPS enzymes, enabling alternative amino acids precursors to be incorporated into the peptide structures. We are optimistic that our new approach could lead to new ways of making improved antibiotics which are urgently needed to combat emerging drug-resistant pathogens.”
Jason Micklefield, Professor, Chemical Biology, Manchester Institute of Biotechnology
Source:
Journal reference:
Thong, W. L., et al. (2021) Gene editing enables rapid engineering of complex antibiotic assembly lines. Nature Communications. doi.org/10.1038/s41467-021-27139-1.